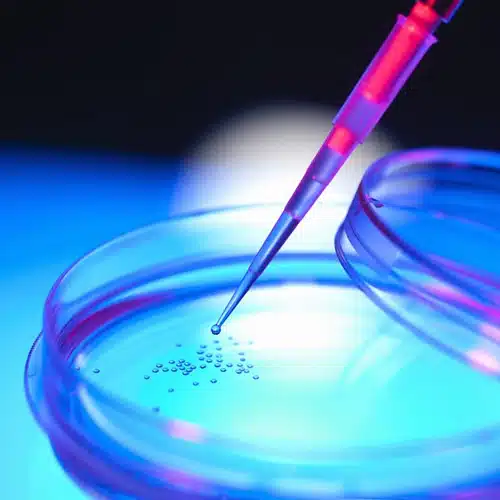
کیت های استخراج
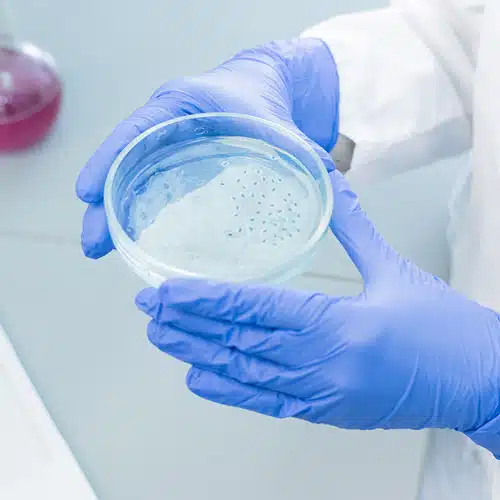
محیط کشت سلولی

صفحه نخست
درباره ما
این شرکت به منظور ارائه محصولات آزمایشگاهی، بخصوص در زمینه ژنتیک و بیوتکنولوژی و محصولات بیولوژی، مولکولی و خدمات مولکولی شروع به فعالیت نمود. از آنجایی که تجربه و تخصص مدیران شرکت در زمینه ژنتیک میباشد ، در این راستا ، سعی در عرضه بهترین محصولات مولکولی از برندهای معتبر ایرانی و خارجی گردیده است.
این شرکت با توجه به داشتن سیاست مشتری مداری و حمایت از مصرف کننده، کلیه اجناس را از برندهای با کیفیت همراه با قیمت مناسب جهت پایین آوردن هزینه مراکز تحقیقاتی و آزمایشگاهی تهیه و ارائه می گرداند و دیگر خریدار دغدغه ی انتخاب در بین شرکتهای مختلف را نخواهد داشت
یکی دیگر از رسالتهای مهم این شرکت تامین کلیه اجناس مورد احتیاج مشتری میباشد، که جهت به وقوع پیوستن این مهم، شرکت مفتخر است با تنوع چند هزار محصول آزمایشگاهی باعث راحتی مشتریها در تامین اجناس مورد نیازشان گردیده است.همچنین در این زمینه مفتخر هستیم با ارائه مشاوره تخصصی در جهت یاری رساندن به مشتریان در انتخاب بهترین محصولات مرتبط با پروژه های دانشجویی و تحقیقاتی حائز بالاترین سطح رضایت مشتریان باشیم .
ما بر این باوریم که ارایه ی محصولات با کیفیت یک استعداد و ویژگی هست
در طول سابقه ی کاری خود ،با افتخار در کنار مشتریانی بوده ایم که در زمان دانشجویی آنها مفتخر به تامین سفارشات آنها بوده ایم و حال در خدمت دانشجویان این اساتید عزیز هستیم.
شرکت زیست فناوری سینوهه متنوعترین و تخصصیترین شرکت توزیعی محصولات آزمایشگاهی و کیتهای بیولوژی مولکولی، ژنتیک و بیوتکنولوژی، محیط های کشت سلولی، محیطهای کشت میکروبی ، مواد شیمیایی و مولکولی، آنزیمهای برشی ، کیتهای الایزا و آنتی بادیها